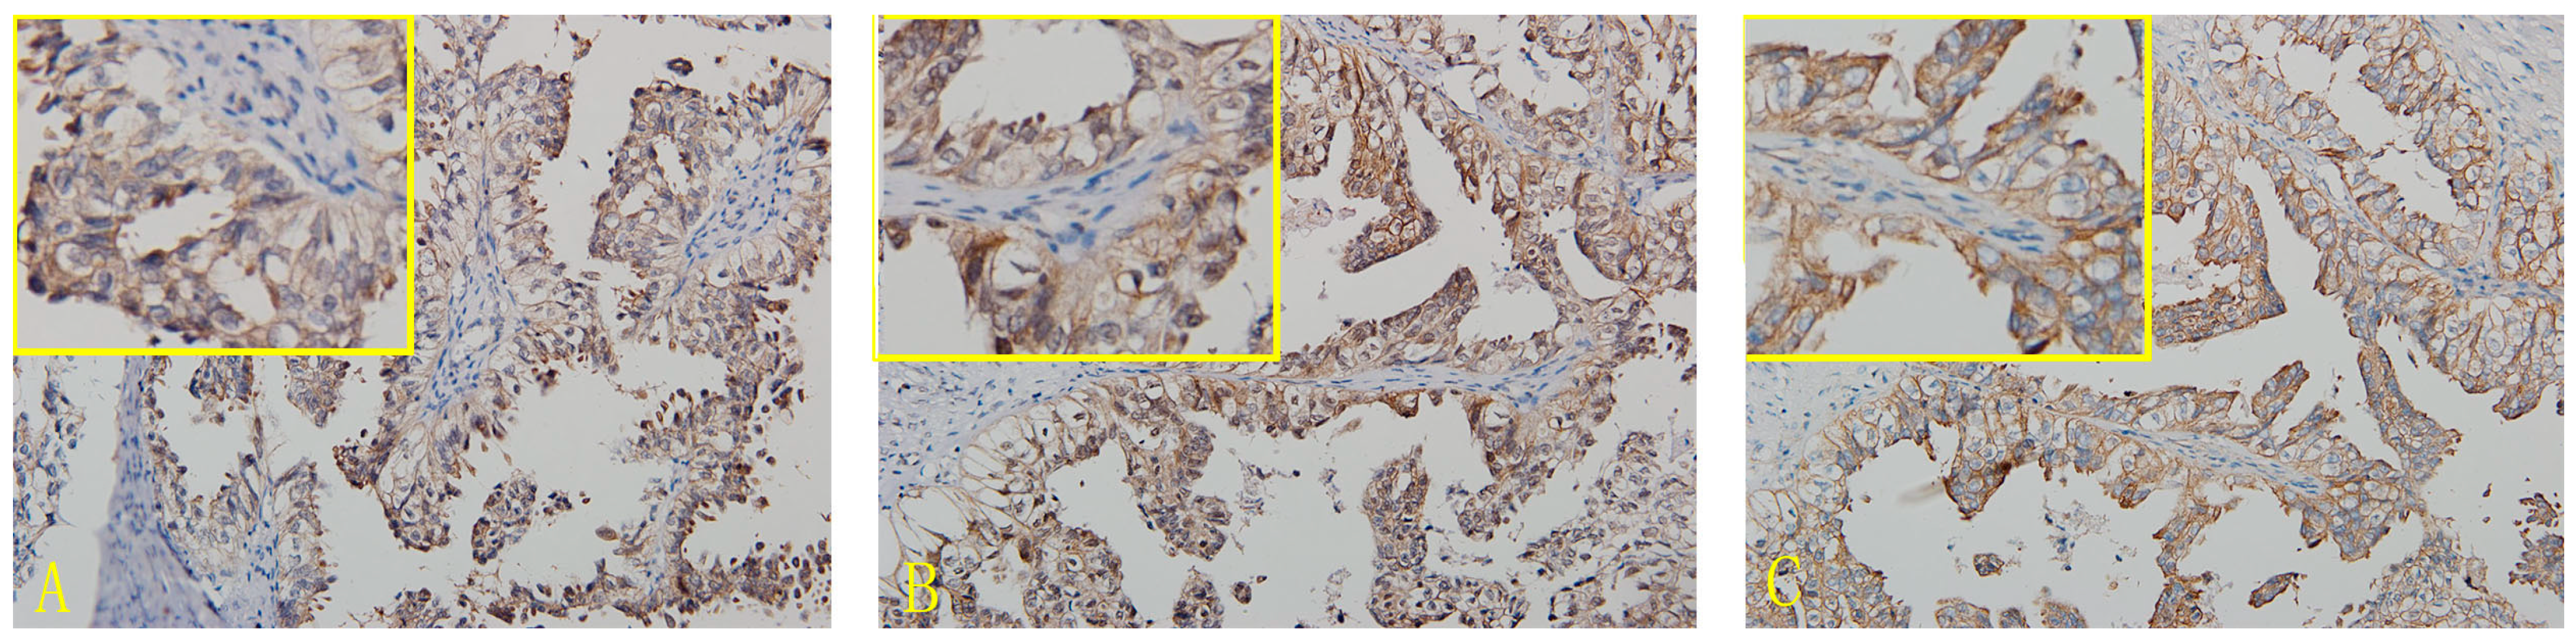
Ijms 16 03391 g001

Expression and Significance of CD44, CD47 and c-met in Ovarian Clear Cell Carcinoma
Abstract
:1. Introduciton
2. Results
2.1. Expression of CD44, CD47 and c-met in OCCC
| Groups | Cases | − | + | ++ | +++ | Positive Cases | Positive Rates (%) |
|---|---|---|---|---|---|---|---|
| CD44 | 86 | 8 | 35 | 26 | 17 | 78 | 90.7 |
| CD47 | 86 | 7 | 27 | 37 | 15 | 79 | 91.9 |
| c-met | 86 | 5 | 21 | 36 | 24 | 81 | 94.2 |
2.2. Relationship between CD44, CD47 and c-met Levels and the Clinicopathological Features of OCCC
| Characteristics | Cases | CD44 | CD47 | c-met | ||||||
|---|---|---|---|---|---|---|---|---|---|---|
| Low | High | p-Value | Low | High | p-Value | Low | High | p-Value | ||
| Surgical stage | 86 | - | - | 0.019 | - | - | 0.001 | - | - | 0.144 |
| I/II | 60 | 35 | 25 | - | 30 | 30 | - | 21 | 39 | - |
| III/IV | 26 | 8 | 18 | - | 4 | 22 | - | 5 | 21 | - |
| Lymph node metastasis * | 84 | - | - | 0.275 | - | - | 0.288 | - | - | 1.000 |
| Yes | 10 | 3 | 7 | - | 2 | 8 | - | 3 | 7 | - |
| No | 74 | 40 | 34 | - | 32 | 42 | - | 23 | 51 | - |
| Chemotherapy | 74 | - | - | 0.001 | 0.015 | - | - | 0.010 | ||
| sensitive | 55 | 34 | 21 | - | 26 | 29 | - | 20 | 35 | - |
| resistant | 19 | 3 | 16 | - | 3 | 16 | - | 1 | 18 | - |
2.3. Risk Factors for OCCC Prognosis
| Variables | p-Value | Hazard Radio (95% CI) |
|---|---|---|
| CD44 (low vs. high) | 0.041 | 3.249 (1.051–10.048) |
| CD47 (low vs. high) | 0.048 | 4.519 (1.014–20.141) |
| c-met (low vs. high) | 0.044 | 7.981 (1.047–60.240) |
| Surgical stage (I–II vs. III–IV) | 0.001 | 5.612 (2.085–15.103) |
2.4. Survival Analysis


2.5. Correlation between CD44, CD47 and c-met Expression
| CD44 | Cases | CD47 | c-met | CD47 | Cases | c-met | |||
|---|---|---|---|---|---|---|---|---|---|
| Negative | Positive | Negative | Positive | Negative | Positive | ||||
| Negative | 8 | 6 | 2 | 5 | 3 | Negative | 7 | 5 | 2 |
| Positive | 78 | 1 | 77 | 0 | 78 | Positive | 79 | 0 | 79 |
| Cases | 86 | 7 | 79 | 5 | 81 | Cases | 86 | 5 | 81 |
| Groups | Surgical Stage | Lymph Node Metastasis * | Chemotherapy | Prognosis | |||||||||
|---|---|---|---|---|---|---|---|---|---|---|---|---|---|
| I/II | III/IV | p-Value | No | Yes | p-Value | Sensitive | Resistant | p-Value | Live (>3 Years) | Dead | p-Value | ||
| CD44/CD47 | CD44-High/ | 17 | 17 | 0.002 * | 28 | 6 | 0.232 ** | 14 | 15 | 0.002 *** | 7 | 15 | 0.000 **** |
| CD44-High/ | 8 | 1 | 8 | 1 | 7 | 1 | 6 | 0 | |||||
| CD44-Low/ | 13 | 5 | 16 | 2 | 15 | 1 | 11 | 2 | |||||
| CD44-Low/ | 22 | 3 | 24 | 1 | 19 | 2 | 19 | 2 | |||||
| CD44-c-met | CD44-High/ | 23 | 15 | 0.024 # | 33 | 5 | 0.247 ## | 20 | 15 | 0.001 ### | 10 | 15 | 0.000 #### |
| CD44-High / | 2 | 3 | 3 | 2 | 2 | 1 | 6 | 0 | |||||
| CD44-Low/ | 18 | 6 | 21 | 3 | 16 | 3 | 10 | 3 | |||||
| CD44-Low/ | 17 | 2 | 19 | 0 | 18 | 0 | 17 | 1 | |||||
| CD47-c-met | CD47-High/ | 20 | 20 | 0.011 & | 39 | 7 | 0.486 && | 24 | 16 | 0.002 &&& | 14 | 16 | 0.000 &&&& |
| CD47-High/ | 4 | 2 | 5 | 1 | 5 | 0 | 4 | 1 | |||||
| CD47-Low/ | 13 | 2 | 14 | 1 | 11 | 2 | 9 | 2 | |||||
| CD47-Low/ | 17 | 2 | 18 | 1 | 15 | 1 | 16 | 0 | |||||
| Cases | 60 | 26 | - | 74 | 10 | - | 55 | 19 | - | 43 | 19 | - | |
3. Discussion
4. Experimental Section
4.1. Patients and Tissue Samples
4.2. Methods
4.2.1. Immunohistochemistry
4.2.2. Assessment Standard
4.3. Statistical Analysis
5. Conclusions
Supplementary Materials
Acknowledgments
Author Contributions
Conflicts of Interest
References
- Ho, C.M.; Wang, Y.J.; Hen, T.C.; Huang, S.H.; Liu, F.S.; Chang Chien, C.C.; Yu, M.H.; Mao, T.L.; Wang, T.Y.; Hsieh, C.Y. Pure-type clear cell carcinoma of the obary as a distinct histological type and improved survival in patients treated with paclitaxel-platinum-based chemotherapy in pure-type advanced disease. Gynecol. Oncol. 2004, 94, 197–203. [Google Scholar] [CrossRef] [PubMed]
- Del Carmen, M.G.; Birrer, M.; Schorge, J.O. Clear cell carcinoma of the ovary: A review of the literature. Gynecol. Oncol. 2012, 126, 481–490. [Google Scholar]
- Fujisaki, T.; Tanaka, Y.; Fujii, K.; Mine, S.; Saito, K.; Yamada, S.; Yamashita, U.; Irimura, T.; Eto, S. CD44 stimulation induces integrin mediated adhesion of colon cancer cell lines to endothelial cells by up regulation of integrins and c-Met and activation of integrins. Cancer Res. 1999, 59, 4427–4434. [Google Scholar]
- Rousseau, V.; Morrison, H.; Matzke, A. Hepatocyte growth factor induced Ras activation requires ERM proteins linked to both CD44V6 and F-Actin. Mol. Biol. Cell. 2007, 18, 76–83. [Google Scholar] [CrossRef] [PubMed]
- Baccelli, I.; Schneeweiss, A.; Stenzinger, A.; Schillert, A.; Vogel, V.; Klein, C.; Saini, M.; Bäuerle, T.; Wallwiener, M.; et al. Identification of a population of blood circulating tumor cells from breast cancer patients that initiates metastasis in a xenograft assay. Nat. Biotechnol. 2013, 31, 539–545. [Google Scholar]
- Rodríguez-Rodríguez, L.; Sancho-Torres, I.; Leakey, P.; Gibbon, D.G.; Comerci, J.T.; Ludlow, J.W.; Mesonero, C. CD44 splice variant expression in clear cell carcinoma of the ovary. Gynecol. Oncol. 1998, 71, 223–229. [Google Scholar] [CrossRef] [PubMed]
- Sancho-Torres, I.; Mesonero, C.; Miller Watelet, J.L.; Gibbon, D.; Rodríguez-Rodríguez, L. Clear cell carcinoma of the ovary: Characterization of its CD44 isoform repertoire. Gynecol. Oncol. 2000, 79, 187–195. [Google Scholar] [CrossRef] [PubMed]
- Yamamoto, S.; Tsuda, H.; Miyai, K.; Takano, M.; Tamai, S.; Matsubara, O. Gene amplification and protein overexpression of MET are common events in ovarian clear-cell adenocarcinoma: Their roles in tumor progression and prognostication of the patient. Mod. Pathol. 2011, 24, 1146–1155. [Google Scholar]
- Baohui, J.; Yuting, H.; Jing, T.; Hui, F.; Linping, H.; Weiping, Y.; Quan, H. In vitro application of anti-CD47 monoclonal antibody for targeted therapy of ovarian cancer. Chin. J. Clin. Oncol. 2013, 40, 440–443. [Google Scholar]
- Manabu, Y.; Yoshiya, T.; Koichi, F.; Yasumoto, K. CD44 stimulation down-regulates Fas expression and Fas-mediated apoptosis of lung cancer cells. Int. Immunol. 2001, 13, 1309–1319. [Google Scholar] [CrossRef] [PubMed]
- Marhaba, R.; Bourouba, M.; Zoller, M. CD44v6 promotes proliferation by persisting activation of MAP kinases. Cell Signal. 2005, 17, 961–973. [Google Scholar] [CrossRef] [PubMed]
- En Kajita, M.; Itoh, Y.; Chiba, T.; Okada, A.; Kinoh, H.; Seiki, M. Membrane-type 1 matrix metalloproteinase cleaves CD44 and promotes cell migration. Cell Biol. 2001, 153, 893–904. [Google Scholar] [CrossRef]
- Sawada, K.; Radjabi, A.R.; Shinomiya, N.; Kistner, E.; Kenny, H.; Becker, A.R.; Turkyilmaz, M.A.; Salgia, R.; Yamada, S.D.; van de Woude, G.F.; et al. c-Met overexpression is a prognostic factor in ovarian cancer and an effective target for inhibition of peritoneal dissemination and invasion. Cancer Res. 2007, 67, 1670–1679. [Google Scholar]
- Matsumura, A.; Kubota, T.; Taiyoh, H.; Fujiwara, H.; Okamoto, K.; Ichikawa, D.; Shiozaki, A.; Komatsu, S.; Nakanishi, M.; Kuriu, Y.; et al. HGF regulates VEGF expression via the c-Met receptor downstream pathways, PI3K/Akt, MAPK and STAT3, in CT26 murine cells. Int. J. Oncol. 2013, 42, 535–542. [Google Scholar]
- Damm, S.; Koefinger, P.; Stefan, M.; Wels, C.; Mehes, G.; Richtig, E.; Kerl, H.; Otte, M.; Schaider, H. HGF Promotes Motility in Primary Human Melanocytes through CD44v6 via a NF-κB/Egr-1/C/EBP-β complex. J. Investig. Dermatol. 2010, 130, 1893–1903. [Google Scholar] [CrossRef] [PubMed]
- Chuan, Y.C.; Iglesias-Gato, D.; Fernandez-Perez, L.; Cedazo-Minguez, A.; Pang, S.T.; Norstedt, G.; Pousette, A.; Flores-Morales, A. Ezrin mediates c-Myc actions in prostate cancer cell invasion. Oncogene 2010, 29, 1531–1542. [Google Scholar] [CrossRef] [PubMed]
- Fehon, R.G.; McClatchey, A.I.; Bretscher, A. Organizing the cell cortex: The role of ERM proteins. Nat. Rev. Mol. Cell. Biol. 2010, 11, 276–287. [Google Scholar] [CrossRef] [PubMed]
- Jun, Sh.; Zhou, Zh.; Wen, D.; Li, N. Correlation of CD44v6 expression with ovarian cancer progression and recurrence. BMC Cancer 2013, 8. [Google Scholar] [CrossRef]
- Zhang, J.; Chang, B.; Liu, J. CD44 standard form expression is correlated with high-grade and advanced-stage ovarian carcinoma but not prognosis. Hum. Pathol. 2013, 44, 1882–1891. [Google Scholar] [CrossRef] [PubMed]
- Matozaki, T.; Murata, Y.; Okazaw, H.; Ohnishi, H. Functions and molecular mechanisms of the CD47-SIRPα signalling pathway. Trends Cell. Biol. 2009, 19, 72–80. [Google Scholar] [CrossRef] [PubMed]
- Kim, M.J.; Lee, J.C.; Lee, J.J.; Kim, S.; Lee, S.G.; Park, S.W.; Sung, M.W.; Heo, D.S. Association of CD47 with natural killer cell-mediated cytotoxicity of head- and neck squamous cell carcinoma lines. Tumour Biol. 2008, 29, 28–34. [Google Scholar] [CrossRef] [PubMed]
- Willingham, S.B.; Volkmer, J.P.; Gentles, A.J.; Sahoo, D.; Dalerba, P.; Mitra, S.S.; Wang, J.; Contreras-Trujillo, H.; Martin, R.; Cohen, J.D.; et al. The CD47-signal regulatory protein alpha (SIRPα) interaction is a therapeutic target for human solid tumors. Proc. Natl. Acad. Sci. USA 2012, 109, 6662–6667. [Google Scholar]
- Jaiswal, S.; Chao, M.P.; Majeti, R.; Weissman, I.L. Macrophages as mediators of tumor immunosurveillance. Trends Immunol. 2010, 31, 212–219. [Google Scholar] [CrossRef] [PubMed]
- Camerlingo, R.; Ferraro, G.A.; de Francesco, F.; Romano, M.; Nicoletti, G.; di Bonito, M.; Rinaldo, M.; D’Andrea, F.; Pirozzi, G. The role of CD44+/CD24−/low biomarker for screening, diagnosis and monitoring of breast cancer. Oncol. Rep. 2014, 31, 1127–1132. [Google Scholar] [PubMed]
- Takaishi, S.; Okaumura, T.; Tu, S.; Wang, S.S.W.; Shibata, W.; Vigneshwaran, R.; Gordon, S.A.K.; Shimada, Y.; Wang, T.C. Identification of gastric cancer stem cells using the cell surface marker CD44. Stem Cells 2009, 27, 1006–1020. [Google Scholar] [CrossRef] [PubMed]
- Chan, K.S.; Espinosa, I.; Chao, M.; Wong, D.; Ailles, L.; Diehn, M.; Gill, H.; Presti, J.; Chang, H.Y.; van de Rijn, M.; et al. Identification, molecular characterization, clinical prognosis, and therapeutic targeting of human bladder tumor-initiating cells. Proc. Natl. Acad. Sci. USA 2009, 106, 14016–14021. [Google Scholar]
- Chan, K.S.; Volkmer, J.P.; Weissman, I. Cancer stem cells in bladder cancer: A revisited and evolving concept. Curr. Opin. Urol. 2010, 20, 393–397. [Google Scholar] [CrossRef] [PubMed]
- Scarpino, S.; Di Napoli, A.; Taraboletti, G.; Cancrini, A.; Ruco, L.P. Hepatocyte growth factor (HGF) downregulates thrombospondin 1 (TSP-1) expression in thyroid papillary carcinoma cells. J. Pathol. 2005, 205, 50–56. [Google Scholar] [CrossRef]
- Shinohara, M.; Ohyama, N.; Murata, Y.; Okazawa, H.; Ohnishi, H.; Ishikawa, O.; Matozaki, T. CD47 regulation of epithelial cell spreading and migration, and its signal transduction. Cancer Sci. 2006, 97, 889–895. [Google Scholar] [CrossRef] [PubMed]
© 2015 by the authors; licensee MDPI, Basel, Switzerland. This article is an open access article distributed under the terms and conditions of the Creative Commons Attribution license (http://creativecommons.org/licenses/by/4.0/).
Share and Cite
Wang, H.; Tan, M.; Zhang, S.; Li, X.; Gao, J.; Zhang, D.; Hao, Y.; Gao, S.; Liu, J.; Lin, B. Expression and Significance of CD44, CD47 and c-met in Ovarian Clear Cell Carcinoma. Int. J. Mol. Sci. 2015, 16, 3391-3404. https://doi.org/10.3390/ijms16023391
Wang H, Tan M, Zhang S, Li X, Gao J, Zhang D, Hao Y, Gao S, Liu J, Lin B. Expression and Significance of CD44, CD47 and c-met in Ovarian Clear Cell Carcinoma. International Journal of Molecular Sciences. 2015; 16(2):3391-3404. https://doi.org/10.3390/ijms16023391
Chicago/Turabian StyleWang, Huimin, Mingzi Tan, Song Zhang, Xiao Li, Jian Gao, Danye Zhang, Yingying Hao, Song Gao, Juanjuan Liu, and Bei Lin. 2015. "Expression and Significance of CD44, CD47 and c-met in Ovarian Clear Cell Carcinoma" International Journal of Molecular Sciences 16, no. 2: 3391-3404. https://doi.org/10.3390/ijms16023391
APA StyleWang, H., Tan, M., Zhang, S., Li, X., Gao, J., Zhang, D., Hao, Y., Gao, S., Liu, J., & Lin, B. (2015). Expression and Significance of CD44, CD47 and c-met in Ovarian Clear Cell Carcinoma. International Journal of Molecular Sciences, 16(2), 3391-3404. https://doi.org/10.3390/ijms16023391
